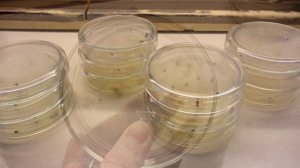

2:52
2:52
2023-12-05 05:28

 3:00
3:00

 3:00
3:00
2023-12-01 15:03

 1:37
1:37

 1:37
1:37
2025-01-23 10:07

 14:38
14:38

 14:38
14:38
2025-03-13 15:38

 1:19
1:19

 1:19
1:19
2023-12-29 13:51

 2:26
2:26

 2:26
2:26
2025-02-09 18:33
!["КНИГА БОБЫ ФЕТТА", 1 СЕРИЯ [ОБЗОР] / КЕМ ПОДАВИЛСЯ САРЛАКК?]() 4:20
4:20
!["КНИГА БОБЫ ФЕТТА", 1 СЕРИЯ [ОБЗОР] / КЕМ ПОДАВИЛСЯ САРЛАКК?](https://pic.rutubelist.ru/video/2024-09-26/8a/0f/8a0fd08b43f75ae3181a257ce3973622.jpg?width=300) 4:20
4:20
2024-09-28 02:32

 2:41
2:41

 2:41
2:41
2024-04-05 15:29

 0:48
0:48

 0:48
0:48
2024-02-04 03:36

 4:13
4:13

 4:13
4:13
2024-04-20 15:17

 38:13
38:13

 38:13
38:13
2024-08-04 15:42

 4:38
4:38
4:38
4:38
2023-08-07 22:51

 3:09
3:09

 3:09
3:09
2023-10-25 15:48

 3:48
3:48

 3:48
3:48
2022-10-22 09:53

 25:49
25:49

 25:49
25:49
2023-10-09 16:45

 16:57
16:57

 16:57
16:57
2023-08-21 15:01

 14:49
14:49

 14:49
14:49
2022-11-27 16:00
![Sekiro Shadows Die Twice - Босс #3 – Генерал Тензен Ямаути]() 1:39
1:39
![KLEO - Люли (Премьера клипа 2025)]() 2:32
2:32
![Соня Белькевич - Подогналась (Премьера клипа 2025)]() 3:13
3:13
![Бекзод Хаккиев - Нолалар (Премьера клипа 2025)]() 4:07
4:07
![Динара Швец - Нас не найти (Премьера клипа 2025)]() 3:46
3:46
![Отабек Муминов - Кетябсан (Премьера клипа 2025)]() 3:17
3:17
![Абрикоса, GOSHU - Удали из памяти (Премьера клипа 2025)]() 4:59
4:59
![Ислам Итляшев - Не реви (Премьера клипа 2025)]() 2:41
2:41
![Бунёд Бобокулов - Отам-онам (Премьера клипа 2025)]() 4:00
4:00
![Даша Эпова - Мой любимый человек (Премьера клипа 2025)]() 2:11
2:11
![10AGE, Роса ft. С. Есенин - Вот уж вечер (Премьера клипа 2025)]() 4:01
4:01
![POLAT - Лунная (Премьера клипа 2025)]() 2:34
2:34
![Инна Вальтер - Татарский взгляд (Премьера клипа 2025)]() 3:14
3:14
![Enrasta - Франция (Премьера клипа 2025)]() 2:44
2:44
![Вика Ветер - Еще поживем (Премьера клипа 2025)]() 4:31
4:31
![UMARO - 1-2-3 (Премьера клипа 2025)]() 2:52
2:52
![АКУЛИЧ - Красные глаза (Премьера клипа 2025)]() 2:13
2:13
![Tural Everest, Руслан Добрый - Красивая (Премьера клипа 2025)]() 3:16
3:16
![Жамоладдин Аматов - Окибат (Премьера клипа 2025)]() 4:38
4:38
![ARTEE - Ты моя (Премьера клипа 2025)]() 3:31
3:31
![Леся Кир - Альфонс (Премьера клипа 2025)]() 3:23
3:23
![Безжалостная | Stone Cold Fox (2025)]() 1:25:31
1:25:31
![Святые из Бундока | The Boondock Saints (1999) (Гоблин)]() 1:48:30
1:48:30
![Пойман с поличным | Caught Stealing (2025)]() 1:46:45
1:46:45
![Битва за битвой | One Battle After Another (2025)]() 2:41:45
2:41:45
![Бешеные псы | Reservoir Dogs (1991) (Гоблин)]() 1:39:10
1:39:10
![Кей-поп-охотницы на демонов | KPop Demon Hunters (2025)]() 1:39:41
1:39:41
![Тот самый | Him (2025)]() 1:36:20
1:36:20
![Протокол выхода | Exit Protocol (2025)]() 1:24:45
1:24:45
![Баллада о маленьком игроке | Ballad of a Small Player (2025)]() 1:42:60
1:42:60
![Школьный автобус | The Lost Bus (2025)]() 2:09:55
2:09:55
![Чёрный телефон 2 | Black Phone 2 (2025)]() 1:53:55
1:53:55
![Только ты | All of You (2025)]() 1:38:22
1:38:22
![Гедда | Hedda (2025)]() 1:48:23
1:48:23
![Терминатор 2: Судный день | Terminator 2: Judgment Day (1991) (Гоблин)]() 2:36:13
2:36:13
![Французский любовник | French Lover (2025)]() 2:02:20
2:02:20
![Рука, качающая колыбель | The Hand That Rocks the Cradle (2025)]() 1:44:57
1:44:57
![Вальсируя с Брандо | Waltzing with Brando (2024)]() 1:44:15
1:44:15
![Дом из динамита | A House of Dynamite (2025)]() 1:55:08
1:55:08
![Чумовая пятница 2 | Freakier Friday (2025)]() 1:50:38
1:50:38
![Я бы тебя пнула, если бы могла | If I Had Legs I'd Kick You (2025)]() 1:53:30
1:53:30
![Команда Дино Сезон 1]() 12:08
12:08
![Паровозик Титипо]() 13:42
13:42
![Сборники «Простоквашино»]() 1:05:35
1:05:35
![Псэмми. Пять детей и волшебство Сезон 1]() 12:17
12:17
![Тайны Медовой долины]() 7:01
7:01
![Последний книжный магазин]() 11:20
11:20
![Сборники «Оранжевая корова»]() 1:05:15
1:05:15
![Сандра - сказочный детектив Сезон 1]() 13:52
13:52
![Таинственные золотые города]() 23:04
23:04
![МегаМен: Полный заряд Сезон 1]() 10:42
10:42
![Пластилинки]() 25:31
25:31
![Команда Дино. Исследователи Сезон 1]() 13:10
13:10
![Люк - путешественник во времени]() 1:19:50
1:19:50
![Шахерезада. Нерассказанные истории Сезон 1]() 23:53
23:53
![Монсики]() 6:30
6:30
![Команда Дино. Исследователи Сезон 2]() 13:26
13:26
![Сборники «Зебра в клеточку»]() 45:30
45:30
![Умка]() 7:11
7:11
![Агент 203]() 21:08
21:08
![Чемпионы]() 7:12
7:12
 1:39
1:39
Скачать Видео с Рутуба / RuTube
| 256x144 | ||
| 640x360 |
 2:32
2:32
2025-11-11 12:30
 3:13
3:13
2025-11-14 11:41
 4:07
4:07
2025-11-11 17:31
 3:46
3:46
2025-11-12 12:20
 3:17
3:17
2025-11-15 12:47
 4:59
4:59
2025-11-15 12:21
 2:41
2:41
2025-11-18 12:35
 4:00
4:00
2025-11-21 13:29
 2:11
2:11
2025-11-15 12:28
 4:01
4:01
2025-11-11 17:26
 2:34
2:34
2025-11-21 13:26
 3:14
3:14
2025-11-18 11:36
 2:44
2:44
2025-11-20 21:37
 4:31
4:31
2025-11-11 12:26
 2:52
2:52
2025-11-14 12:21
 2:13
2:13
2025-11-15 12:35
 3:16
3:16
2025-11-12 12:12
 4:38
4:38
2025-11-11 17:38
 3:31
3:31
2025-11-14 19:59
 3:23
3:23
2025-11-19 11:51
0/0
 1:25:31
1:25:31
2025-11-10 21:11
 1:48:30
1:48:30
2025-09-23 22:53
 1:46:45
1:46:45
2025-10-02 20:45
 2:41:45
2:41:45
2025-11-14 13:17
 1:39:10
1:39:10
2025-09-23 22:53
 1:39:41
1:39:41
2025-10-29 16:30
 1:36:20
1:36:20
2025-10-09 20:02
 1:24:45
1:24:45
2025-11-13 23:26
 1:42:60
1:42:60
2025-10-31 10:53
 2:09:55
2:09:55
2025-10-05 00:32
 1:53:55
1:53:55
2025-11-05 19:47
 1:38:22
1:38:22
2025-10-01 12:16
 1:48:23
1:48:23
2025-11-05 19:47
 2:36:13
2:36:13
2025-10-07 09:27
 2:02:20
2:02:20
2025-10-01 12:06
 1:44:57
1:44:57
2025-10-29 16:30
 1:44:15
1:44:15
2025-11-07 20:19
 1:55:08
1:55:08
2025-10-29 16:30
 1:50:38
1:50:38
2025-10-16 16:08
 1:53:30
1:53:30
2025-11-20 21:03
0/0
2021-09-22 22:29
 13:42
13:42
2024-11-28 14:12
 1:05:35
1:05:35
2025-10-31 17:03
2021-09-22 22:23
 7:01
7:01
2022-03-30 17:25
 11:20
11:20
2025-09-12 10:05
 1:05:15
1:05:15
2025-09-30 13:45
2021-09-22 20:39
 23:04
23:04
2025-01-09 17:26
2021-09-22 21:43
 25:31
25:31
2022-04-01 14:30
2021-09-22 22:45
 1:19:50
1:19:50
2024-12-17 16:00
2021-09-22 23:25
 6:30
6:30
2022-03-29 19:16
2021-09-22 22:54
 45:30
45:30
2025-09-17 18:49
 7:11
7:11
2025-01-13 11:05
 21:08
21:08
2025-01-09 16:39
 7:12
7:12
2025-11-21 03:26
0/0

